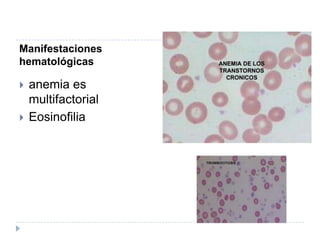
Manifestaciones hematológicasanemia es multifactorialEosinofilia

La artritis reumatoide (AR) es una enfermedad inflamatoria crónica que afecta principalmente las articulaciones periféricas de manera simétrica, causando dolor, hinchazón e inflamación. La AR se caracteriza por la inflamación de la membrana sinovial y la destrucción progresiva del cartílago y el hueso subyacente. Además de las manifestaciones articulares, la AR puede causar síntomas en otros órganos. No existe cura para la AR, pero el tratamiento temprano y agres